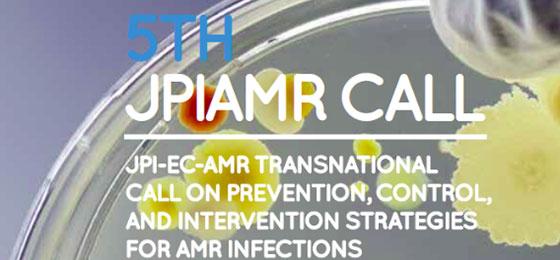

Cinq autres projets JPIAMR dans le PNR 72
Le PNR 72 participe à cinq autres projets de recherche transnationaux. Il s'agit d'études de prévention et d'intervention en médecine humaine et vétérinaire qui visent à améliorer l'utilisation des antibiotiques.
Le PNR 72 soutient financièrement les projets partiels suisses compris dans cinq projets de recherche internationaux. Actuellement 26 pays participent à ces projets coordonnés au sein de la Joint Programming Initiative on Antimicrobial Resistance (JPIAMR). Les projets partiels suisses retenus correspondent aux buts du PNR 72, en particulier à ceux du module 3, qui préconise une utilisation plus circonspecte des antibiotiques en médecine humaine et vétérinaire pour maintenir l'efficacité des antibiotiques connus.
